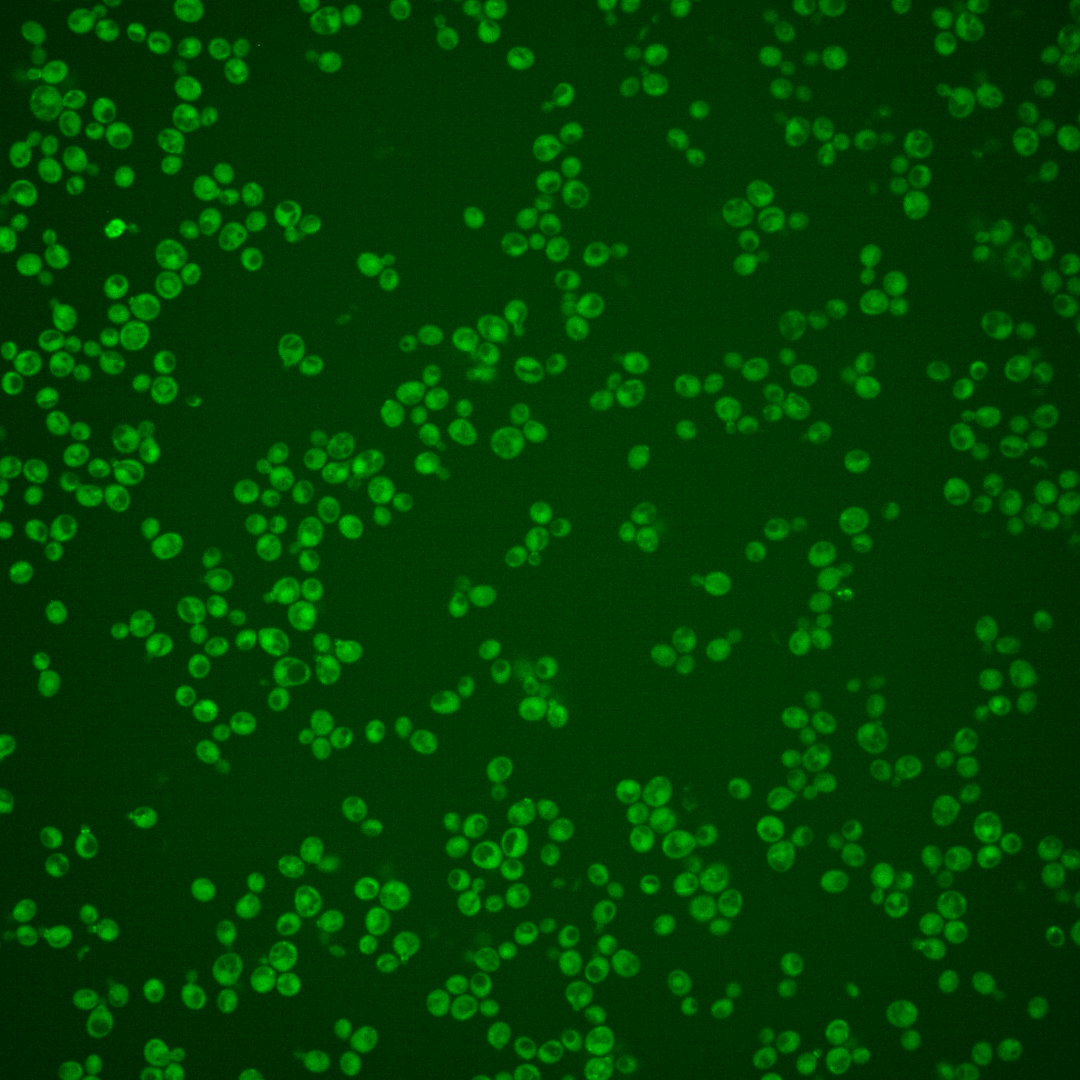

| Standard name | |
|---|---|
| Human Ortholog | |
| Description | Protein kinase of the bud neck involved in the septin checkpoint; associates with septin proteins, negatively regulates Swe1p by phosphorylation, shows structural homology to bud neck kinases Gin4p and Hsl1p; KCC4 has a paralog, GIN4, that arose from the whole genome duplication |
Micrographs




















































































Sub-cellular Localization
Yeast GFP Assignment
Protein Abundance
Localization Change
External localization resources
| ensLOC | DeepLoc | |||||||||||||||||||||||
|---|---|---|---|---|---|---|---|---|---|---|---|---|---|---|---|---|---|---|---|---|---|---|---|---|
| Localization | WT1 | WT2 | WT3 | RAP60 | RAP140 | RAP220 | RAP300 | RAP380 | RAP460 | RAP540 | RAP620 | RAP700 | HU80 | HU120 | HU160 | rpd3Δ_1 | rpd3Δ_2 | rpd3Δ_3 | WT1 | WT2 | WT3 | AF100 | AF140 | AF180 |
| Cortical Patches | 4 | 1 | 3 | 5 | 0 | 4 | 4 | 0 | 2 | 3 | 2 | 0 | 5 | 5 | 0 | 17 | 7 | 13 | 8 | 6 | 8 | 2 | 2 | 12 |
| Bud | 3 | 1 | 7 | 9 | 16 | 14 | 20 | 19 | 10 | 18 | 15 | 15 | 8 | 18 | 27 | 12 | 6 | 9 | 7 | 4 | 4 | 0 | 2 | 9 |
| Bud Neck | 2 | 0 | 6 | 10 | 14 | 14 | 19 | 22 | 8 | 7 | 6 | 8 | 13 | 12 | 1 | 13 | 15 | 15 | 19 | 9 | 12 | 10 | 1 | 4 |
| Bud Site | 2 | 0 | 4 | 6 | 3 | 5 | 3 | 11 | 3 | 2 | 4 | 6 | 6 | 1 | 4 | 2 | 3 | 3 | – | – | – | – | – | – |
| Cell Periphery | 2 | 0 | 1 | 0 | 2 | 2 | 1 | 2 | 3 | 2 | 1 | 6 | 1 | 1 | 1 | 5 | 4 | 3 | 0 | 0 | 2 | 0 | 1 | 2 |
| Cytoplasm | 93 | 36 | 83 | 171 | 239 | 310 | 390 | 505 | 217 | 269 | 180 | 297 | 272 | 317 | 415 | 111 | 105 | 208 | 75 | 45 | 59 | 55 | 343 | 354 |
| Endoplasmic Reticulum | 2 | 1 | 1 | 1 | 0 | 0 | 2 | 0 | 0 | 1 | 2 | 0 | 1 | 0 | 0 | 7 | 3 | 19 | 1 | 0 | 0 | 0 | 0 | 4 |
| Endosome | 0 | 0 | 0 | 0 | 0 | 0 | 0 | 0 | 0 | 0 | 0 | 0 | 3 | 7 | 4 | 1 | 1 | 3 | 5 | 1 | 2 | 2 | 0 | 4 |
| Golgi | 0 | 0 | 0 | 0 | 0 | 0 | 0 | 0 | 0 | 0 | 0 | 0 | 1 | 0 | 0 | 0 | 0 | 1 | 0 | 0 | 0 | 0 | 0 | 1 |
| Mitochondria | 15 | 14 | 13 | 21 | 20 | 61 | 113 | 167 | 117 | 136 | 116 | 217 | 9 | 0 | 20 | 4 | 2 | 4 | 8 | 7 | 15 | 3 | 4 | 11 |
| Nucleus | 1 | 0 | 0 | 0 | 1 | 0 | 1 | 7 | 0 | 0 | 1 | 1 | 1 | 1 | 0 | 1 | 1 | 1 | 0 | 0 | 0 | 0 | 1 | 0 |
| Nuclear Periphery | 1 | 0 | 0 | 1 | 0 | 0 | 2 | 1 | 1 | 1 | 1 | 0 | 1 | 1 | 0 | 0 | 0 | 0 | 0 | 1 | 0 | 0 | 0 | 1 |
| Nucleolus | 1 | 0 | 0 | 0 | 1 | 0 | 0 | 0 | 0 | 0 | 0 | 0 | 0 | 0 | 0 | 0 | 0 | 0 | 0 | 0 | 0 | 0 | 0 | 0 |
| Peroxisomes | 0 | 0 | 0 | 0 | 2 | 0 | 0 | 0 | 0 | 1 | 0 | 0 | 3 | 3 | 2 | 0 | 0 | 1 | 1 | 0 | 0 | 0 | 0 | 0 |
| SpindlePole | 1 | 0 | 1 | 2 | 9 | 7 | 9 | 16 | 6 | 2 | 12 | 15 | 10 | 2 | 1 | 7 | 7 | 16 | 3 | 2 | 5 | 1 | 1 | 6 |
| Vac/Vac Membrane | 0 | 1 | 0 | 0 | 0 | 0 | 1 | 0 | 1 | 0 | 0 | 2 | 0 | 1 | 0 | 1 | 0 | 1 | 2 | 2 | 2 | 2 | 3 | 3 |
| Unique Cell Count | 115 | 46 | 100 | 196 | 277 | 363 | 477 | 634 | 296 | 359 | 273 | 439 | 311 | 352 | 447 | 144 | 127 | 251 | 139 | 82 | 117 | 84 | 372 | 424 |
| Labelled Cell Count | 127 | 54 | 119 | 226 | 307 | 417 | 565 | 750 | 368 | 442 | 340 | 567 | 334 | 369 | 475 | 181 | 154 | 297 | 139 | 82 | 117 | 84 | 372 | 424 |
Yeast GFP Assignment
Protein Abundance
| Screen | WT1 | WT2 | WT3 | RAP60 | RAP140 | RAP220 | RAP300 | RAP380 | RAP460 | RAP540 | RAP620 | RAP700 | HU80 | HU120 | HU160 | rpd3Δ_1 | rpd3Δ_2 | rpd3Δ_3 | AF100 | AF140 | AF180 |
|---|---|---|---|---|---|---|---|---|---|---|---|---|---|---|---|---|---|---|---|---|---|
| Mean Cell GFP Intensity (1e-4) | 4.1 | 3.4 | 2.9 | 2.8 | 3.1 | 2.8 | 2.6 | 2.7 | 2.3 | 2.4 | 2.4 | 2.1 | 4.3 | 4.3 | 3.7 | 5.2 | 5.2 | 5.9 | 4.0 | 3.9 | 4.5 |
| Std Deviation (1e-4) | 0.6 | 0.8 | 0.4 | 0.6 | 1.0 | 0.7 | 0.9 | 0.6 | 0.6 | 1.1 | 1.0 | 0.7 | 0.9 | 0.7 | 0.7 | 0.9 | 1.0 | 1.8 | 1.4 | 0.9 | 1.5 |
| Intensity Change (Log2) | – | – | – | -0.02 | 0.13 | -0.02 | -0.12 | -0.08 | -0.31 | -0.28 | -0.25 | -0.42 | 0.57 | 0.57 | 0.38 | 0.85 | 0.86 | 1.03 | 0.5 | 0.44 | 0.64 |
Localization Change
| Localization | RAP60 | RAP140 | RAP220 | RAP300 | RAP380 | RAP460 | RAP540 | RAP620 | RAP700 | HU80 | HU120 | HU160 | rpd3Δ_1 | rpd3Δ_2 | rpd3Δ_3 |
|---|---|---|---|---|---|---|---|---|---|---|---|---|---|---|---|
| Actin | – | – | – | – | – | – | – | – | – | – | – | – | – | – | – |
| Bud | – | – | – | – | – | – | – | – | – | – | – | – | – | – | – |
| Bud Neck | – | – | – | – | – | – | – | – | – | – | – | – | – | – | – |
| Bud Site | – | – | – | – | – | – | – | – | – | – | – | – | – | – | – |
| Cell Periphery | – | – | – | – | – | – | – | – | – | – | – | – | – | – | – |
| Cyto | – | – | – | – | – | – | – | – | – | – | – | – | – | – | – |
| Endoplasmic Reticulum | – | – | – | – | – | – | – | – | – | – | – | – | – | – | – |
| Endosome | – | – | – | – | – | – | – | – | – | – | – | – | – | – | – |
| Golgi | – | – | – | – | – | – | – | – | – | – | – | – | – | – | – |
| Mitochondria | – | – | – | – | – | – | – | – | – | – | – | – | – | – | – |
| Nuclear Periphery | – | – | – | – | – | – | – | – | – | – | – | – | – | – | – |
| Nuc | – | – | – | – | – | – | – | – | – | – | – | – | – | – | – |
| Nucleolus | – | – | – | – | – | – | – | – | – | – | – | – | – | – | – |
| Peroxisomes | – | – | – | – | – | – | – | – | – | – | – | – | – | – | – |
| SpindlePole | – | – | – | – | – | – | – | – | – | – | – | – | – | – | – |
| Vac | – | – | – | – | – | – | – | – | – | – | – | – | – | – | – |
| Cortical Patches | – | – | – | – | – | – | – | – | – | – | – | – | – | – | – |
| Cytoplasm | – | – | – | – | – | – | – | – | – | – | – | – | – | – | – |
| Nucleus | – | – | – | – | – | – | – | – | – | – | – | – | – | – | – |
| Vacuole | – | – | – | – | – | – | – | – | – | – | – | – | – | – | – |
External localization resources
Images






























Protein Concentration and Protein Localization Data
| R1 | R2 | R3 | ||||||||||||||||
|---|---|---|---|---|---|---|---|---|---|---|---|---|---|---|---|---|---|---|
| G1 Pre-START | G1 Post-START | S/G2 | Metaphase | Anaphase | Telophase | G1 Pre-START | G1 Post-START | S/G2 | Metaphase | Anaphase | Telophase | G1 Pre-START | G1 Post-START | S/G2 | Metaphase | Anaphase | Telophase | |
| Concentration | 0.2511 | -0.3931 | -0.3621 | -0.8635 | 1.8822 | -0.713 | 1.1115 | 0.9818 | 1.4111 | 0.9589 | 0.7021 | 0.6688 | -1.7338 | -0.9157 | -0.8131 | -1.0187 | -1.0179 | -0.9329 |
| Actin | 0.1659 | 0.0067 | 0.0265 | 0.0042 | 0.1289 | 0.0041 | 0.1075 | 0.0011 | 0.0367 | 0.002 | 0.0323 | 0.0143 | 0.0007 | 0.0006 | 0.0149 | 0.0022 | 0.0083 | 0.0075 |
| Bud | 0.0026 | 0.008 | 0.0094 | 0.0003 | 0.0161 | 0.0003 | 0.0042 | 0.001 | 0.0014 | 0.0008 | 0.0005 | 0.0003 | 0.0007 | 0.0052 | 0.0006 | 0.0004 | 0.0002 | 0.0001 |
| Bud Neck | 0.0188 | 0.0177 | 0.3706 | 0.4938 | 0.0088 | 0.1569 | 0.0234 | 0.0121 | 0.3487 | 0.27 | 0.0916 | 0.0615 | 0.0134 | 0.0209 | 0.2877 | 0.2509 | 0.0594 | 0.0739 |
| Bud Periphery | 0.0042 | 0.0043 | 0.007 | 0.0004 | 0.0287 | 0.0005 | 0.0095 | 0.0008 | 0.0017 | 0.0011 | 0.001 | 0.0004 | 0.0013 | 0.0031 | 0.0012 | 0.0005 | 0.0004 | 0.0002 |
| Bud Site | 0.0444 | 0.1046 | 0.1343 | 0.0016 | 0.0187 | 0.0011 | 0.0808 | 0.2129 | 0.0998 | 0.01 | 0.002 | 0.0008 | 0.0727 | 0.1433 | 0.0707 | 0.0006 | 0.0007 | 0.0014 |
| Cell Periphery | 0.0024 | 0.0028 | 0.0028 | 0.0005 | 0.0048 | 0.0003 | 0.0018 | 0.0018 | 0.0014 | 0.0008 | 0.0006 | 0.0002 | 0.0015 | 0.0021 | 0.0029 | 0.0005 | 0.0001 | 0.0003 |
| Cytoplasm | 0.0723 | 0.1334 | 0.0584 | 0.139 | 0.263 | 0.1732 | 0.1543 | 0.2119 | 0.1494 | 0.2976 | 0.2232 | 0.3661 | 0.0465 | 0.0363 | 0.0477 | 0.0344 | 0.0554 | 0.0521 |
| Cytoplasmic Foci | 0.0352 | 0.0266 | 0.041 | 0.0299 | 0.007 | 0.0174 | 0.0511 | 0.0177 | 0.024 | 0.022 | 0.0269 | 0.0102 | 0.0147 | 0.0076 | 0.0204 | 0.01 | 0.0097 | 0.0116 |
| Eisosomes | 0.003 | 0.0012 | 0.0015 | 0.0003 | 0.0011 | 0.0002 | 0.001 | 0.0002 | 0.0006 | 0.0003 | 0.0006 | 0.0001 | 0.0006 | 0.0009 | 0.0026 | 0.0008 | 0.0003 | 0.0004 |
| Endoplasmic Reticulum | 0.0094 | 0.0015 | 0.0013 | 0.0009 | 0.0146 | 0.0013 | 0.0032 | 0.0007 | 0.0028 | 0.0006 | 0.0014 | 0.0023 | 0.0015 | 0.0005 | 0.0005 | 0.0004 | 0.0005 | 0.0004 |
| Endosome | 0.0414 | 0.0028 | 0.0045 | 0.0128 | 0.0654 | 0.0058 | 0.0267 | 0.011 | 0.0145 | 0.0019 | 0.0143 | 0.0072 | 0.0048 | 0.0003 | 0.0009 | 0.0003 | 0.0071 | 0.0068 |
| Golgi | 0.0191 | 0.0007 | 0.0029 | 0.0016 | 0.0137 | 0.0025 | 0.0177 | 0.001 | 0.0103 | 0.0003 | 0.0311 | 0.0059 | 0.0003 | 0.0001 | 0.0015 | 0.0001 | 0.0052 | 0.0061 |
| Lipid Particles | 0.0116 | 0.0018 | 0.0059 | 0.017 | 0.0028 | 0.0031 | 0.0253 | 0.001 | 0.0104 | 0.0001 | 0.0157 | 0.0017 | 0.0048 | 0.0004 | 0.0025 | 0.0005 | 0.0244 | 0.0029 |
| Mitochondria | 0.0319 | 0.0044 | 0.002 | 0.0548 | 0.017 | 0.003 | 0.0224 | 0.0002 | 0.0048 | 0.0004 | 0.0488 | 0.0039 | 0.0004 | 0.0005 | 0.0021 | 0.0003 | 0.0072 | 0.0013 |
| None | 0.4836 | 0.672 | 0.3107 | 0.2343 | 0.2316 | 0.6242 | 0.4085 | 0.5182 | 0.2689 | 0.387 | 0.4947 | 0.5205 | 0.8301 | 0.7732 | 0.53 | 0.6809 | 0.7817 | 0.8288 |
| Nuclear Periphery | 0.0193 | 0.0003 | 0.0012 | 0.0005 | 0.0775 | 0.0008 | 0.0144 | 0.0004 | 0.0058 | 0.0002 | 0.0006 | 0.0012 | 0.001 | 0.0002 | 0.0002 | 0.0007 | 0.0014 | 0.0011 |
| Nucleolus | 0.0019 | 0.0038 | 0.002 | 0.0005 | 0.0039 | 0.0003 | 0.0012 | 0.0002 | 0.0008 | 0.0003 | 0.0003 | 0.0001 | 0.0007 | 0.0011 | 0.0016 | 0.0018 | 0.0002 | 0.0002 |
| Nucleus | 0.0053 | 0.0022 | 0.002 | 0.0011 | 0.0586 | 0.0013 | 0.0035 | 0.001 | 0.0033 | 0.0014 | 0.0006 | 0.0009 | 0.0009 | 0.0018 | 0.0014 | 0.003 | 0.0003 | 0.0003 |
| Peroxisomes | 0.0088 | 0.0018 | 0.0069 | 0.0019 | 0.0013 | 0.0003 | 0.0225 | 0.0011 | 0.0092 | 0.0002 | 0.0095 | 0.0011 | 0.0004 | 0.0004 | 0.0074 | 0.0003 | 0.0344 | 0.0011 |
| Punctate Nuclear | 0.0099 | 0.0017 | 0.0078 | 0.0009 | 0.0022 | 0.0011 | 0.0069 | 0.0039 | 0.0041 | 0.0007 | 0.0013 | 0.0009 | 0.0018 | 0.0012 | 0.0026 | 0.0108 | 0.0021 | 0.0029 |
| Vacuole | 0.0055 | 0.0016 | 0.0012 | 0.0021 | 0.0206 | 0.0014 | 0.0108 | 0.0015 | 0.0008 | 0.0022 | 0.0018 | 0.0004 | 0.001 | 0.0005 | 0.0005 | 0.0005 | 0.0004 | 0.0002 |
| Vacuole Periphery | 0.0034 | 0.0001 | 0.0002 | 0.0016 | 0.0138 | 0.001 | 0.0035 | 0.0002 | 0.0006 | 0.0001 | 0.0012 | 0.0002 | 0.0001 | 0 | 0.0001 | 0.0001 | 0.0004 | 0.0001 |
Sequencing Data
| R1 | R2 | |||||||||
|---|---|---|---|---|---|---|---|---|---|---|
| G1 Post-START | S/G2 | Metaphase | Anaphase | Telophase | G1 Post-START | S/G2 | Metaphase | Anaphase | Telophase | |
| Gene Expression | 17.0082 | 2.2173 | 5.6411 | 13.9592 | 13.5527 | 23.0191 | 5.6848 | 4.8636 | 10.6064 | 20.8917 |
| Translational Efficiency | – | – | – | – | – | – | – | – | – | – |
Hit Data
| Dataset | Hit |
|---|---|
| Protein Concentration | ✘ |
| Protein Localization | ✘ |
| Gene Expression | ✔ |
| Translational Efficiency | – |
Endocytosis
| Temp | Actin Patch (Sac6-tdTomato) | Cortical Patch (Sla1-GFP) | Late Endosome (Snf7-GFP) | Vacuole (Vph1-GFP) |
|---|---|---|---|---|
| 37℃ | ||||
| RT |
Cell Cycle Omics
CYCLoPs (Kcc4-GFP)
| Gene / Allele | Actin Patch (Sac6-tdTomato) | Cortical Patch (Sla1-GFP) | Late Endosome (Snf7-GFP) | Vacuole (Sac6-tdTomato) |
|---|
| Gene | Images |
|---|
| Gene | Images |
|---|
Images are not yet available
Images are not yet available